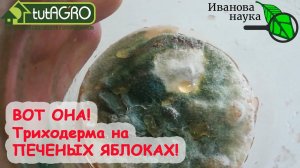
ЯБЛОЧНАЯ ТРИХОДЕРМА. Пошаговый рецепт приготовления ТРИХОДЕРМЫ на ЦЕЛЬНЫХ ЯБЛОКАХ. Суперпродукт!

6:15
6:15
2025-08-28 17:12

 5:27
5:27

 5:27
5:27
2026-05-06 19:38

 5:22
5:22
5:22
5:22
2022-10-25 15:00

 15:43
15:43

 15:43
15:43
КАК ВЫРАСТИТЬ ТРИХОДЕРМУ ИЗ ЗАКВАСКИ ТРИХОДЕРМА MIX. По шагам, признаки готовности и сроки годности.
2023-10-03 14:13

 4:58
4:58

 4:58
4:58
2025-02-25 16:00

 5:00
5:00

 5:00
5:00
2023-08-14 18:07

 2:25:54
2:25:54

 2:25:54
2:25:54
2025-09-23 21:01

 58:33
58:33

 58:33
58:33
2026-06-10 15:09

 1:40:01
1:40:01

 1:40:01
1:40:01
2026-05-28 16:01

 1:32:57
1:32:57

 1:32:57
1:32:57
2023-12-04 22:55

 2:37:54
2:37:54

 2:37:54
2:37:54
2026-06-09 21:00

 1:02:50
1:02:50

 1:02:50
1:02:50
2026-06-10 08:00

 1:57:45
1:57:45

 1:57:45
1:57:45
2026-06-07 21:00

 1:02:36
1:02:36

 1:02:36
1:02:36
2025-08-07 08:57

 2:08:07
2:08:07

 2:08:07
2:08:07
2025-03-07 12:00

 53:39
53:39

 53:39
53:39
Вечер на радио Sputnik с Дмитрием Пучковым| Отмена дипломных работ в вузах и диалог России и Армении
2026-06-10 07:27

 3:06:33
3:06:33

 3:06:33
3:06:33
2024-12-19 09:22

 2:01:45
2:01:45
![Ислам Итляшев - Мужское сердце (Премьера клипа 2026)]() 3:24
3:24
![Рейсан Магомедкеримов - Роза алая (Премьера клипа 2026)]() 3:52
3:52
![Гоша Куценко, Юлия Пак - Твоя я (Премьера клипа 2026)]() 4:01
4:01
![Соня Белькевич - Давай, танцуй (Премьера клипа 2026)]() 3:40
3:40
![Винтаж - Малахит (Премьера клипа 2026)]() 3:44
3:44
![Сергей Одинцов - Моя недотрога (Премьера клипа 2026)]() 3:40
3:40
![Рейсан Магомедкеримов - Судьба связала (Премьера клипа 2026)]() 3:10
3:10
![Ярослав Леонов - Майская роза (Премьера клипа 2026)]() 3:14
3:14
![Enrasta - Адьёс (Премьера клипа 2026)]() 3:45
3:45
![Альберт Эркенов - По привычке (Премьера клипа 2026)]() 2:54
2:54
![Гоша Грачевский - Домой (Премьера клипа 2026)]() 2:50
2:50
![Группа КАРОЛИНА - Розовые краски (Премьера клипа 2026)]() 4:06
4:06
![Cvetocek7 - Близкий человек (Премьера клипа 2026)]() 2:46
2:46
![SHAXO, ILIMA - Чувства (Премьера клипа 2026)]() 2:34
2:34
![Руслан Добрый - Итальянка (Премьера клипа 2026)]() 2:14
2:14
![Ислам Итляшев - На руках (Премьера клипа 2026)]() 3:02
3:02
![Рейсан Магомедкеримов - На рахате (Премьера клипа 2026)]() 2:44
2:44
![Стас Михайлов, Люся Чеботина - Обнимай (Премьера клипа 2026)]() 3:40
3:40
![SEREBRO - Мало огня (Премьера клипа 2026)]() 1:52
1:52
![Murat Gamidov - По ночам (Премьера клипа 2026)]() 2:53
2:53
![Полный такос | Operation Taco Gary's (2026)]() 1:26:14
1:26:14
![Крик 7 | Scream 7 (2026)]() 1:53:59
1:53:59
![GOAT: Мечтай по-крупному | GOAT (2026)]() 1:39:46
1:39:46
![Трон: Арес | Tron: Ares (2025)]() 1:52:27
1:52:27
![Компаньон | Companion (2025)]() 1:37:08
1:37:08
![Невеста! | The Bride! (2026)]() 2:06:44
2:06:44
![Мумия | The Mummy (2026)]() 2:15:22
2:15:22
![Грозовой перевал | Wuthering Heights (2026)]() 2:16:14
2:16:14
![Тайны моей сестры | My Sister's Bones (2026)]() 1:21:23
1:21:23
![Обитель зла 4: Жизнь после смерти 3D | Resident Evil: Afterlife (2010)]() 1:37:36
1:37:36
![Они придут за тобой | They Will Kill You (2026)]() 1:35:38
1:35:38
![Последствия | Outcome (2026)]() 1:23:53
1:23:53
![Зараза | Cold Storage (2025)]() 1:39:05
1:39:05
![Острые козырьки: Бессмертный человек | Peaky Blinders: The Immortal Man (2026)]() 1:54:08
1:54:08
![Вершина | Apex (2026)]() 1:35:30
1:35:30
![Дьявол носит Prada 2 | The Devil Wears Prada 2 (2026)]() 1:51:51
1:51:51
![Джек Райан: Призрачная война | Jack Ryan: Ghost War (2026)]() 1:46:53
1:46:53
![Супер Марио: Галактическое кино | The Super Mario Galaxy Movie (2026)]() 1:38:05
1:38:05
![Смертельно прекрасна | Pretty Lethal (2026)]() 1:30:46
1:30:46
![Проект «Конец света» | Project Hail Mary (2026)]() 2:36:26
2:36:26
![Сборники «Приключения Пети и Волка»]() 1:28:31
1:28:31
![Герой внутри]() 1:09
1:09
![Пип и Альба. Приключения в Соленой Бухте! Сезон 1]() 11:02
11:02
![Отряд А. Игрушки-спасатели]() 13:06
13:06
![Мотофайтеры]() 13:10
13:10
![Мия и Коди]() 0:12
0:12
![Сандра - сказочный детектив Сезон 1]() 13:52
13:52
![Панда и петушок Лука]() 12:12
12:12
![Чебурашка]() 7:00
7:00
![Панда и Антилопа]() 12:08
12:08
![Корги по имени Моко. Новый питомец]() 3:28
3:28
![МегаМен: Полный заряд Сезон 1]() 10:42
10:42
![Супер Зак]() 11:38
11:38
![Минифорс. Сила динозавров]() 12:51
12:51
![Игрушечный полицейский Сезон 1]() 7:19
7:19
![Богатырята]() 11:00
11:00
![Космический рейнджер Роджер Сезон 1]() 11:32
11:32
![Салон дядюшки Брэда]() 1:02
1:02
![Майло]() 0:25
0:25
![Школьный автобус Гордон]() 12:34
12:34
![КЛИПЫ 80-90 х - ЗОЛОТЫЕ ХИТЫ - ЛЮБИМЫЕ ПЕСНИ]() 2:07:05
2:07:05
![Дьявол носит Prada | The Devil Wears Prada (2006)]() 1:49:29
1:49:29
![Антиреспект - Тишины хочу]() 4:33
4:33
![MAUR - Полетела (Премьера клипа 2025)]() 2:53
2:53
![Три Кота 🐱 Сборник серий подряд | Смотреть онлайн развивающие мультики и игры для детей и малышей]() 3:16:51
3:16:51
![Барбоскины 1-30]() 2:21:36
2:21:36
![Сборник Новогодняя Десятка - Уральские Пельмени]() 1:19:08
1:19:08
![Ми–Ми–Мишки 💫 Звездная история 🙃 Все серии ✨ Мультики для детей]() 2:10:31
2:10:31
![Цып-Цып - Мультики для детей - Все серии подряд!]() 1:45:28
1:45:28
![Клипы 90-х. Русский сборник хитов]() 1:29:27
1:29:27
![Сборник На Кухне | Уральские Пельмени]() 1:30:27
1:30:27
![Давид | David (2025)]() 1:49:18
1:49:18
![Три Кота | Сборник домашних приключений | Мультфильмы для детей]() 45:14
45:14
![мультфильм «Ну, погоди!» (1-16 серии)]() 2:31:36
2:31:36
![Дискотека 80-х 90-х Сборник видеоклипов (продолжение)]() 1:16:25
1:16:25
![Сборник Топ 20 Номеров за 2024 год - Уральские Пельмени]() 2:52:30
2:52:30
![Алдан (2025)]() 1:38:04
1:38:04
![ТОП ЛУЧШИХ КЛИПОВ ШАНСОНА - Слушать шансон лучшее.]() 3:48:45
3:48:45
![Буба - Все серии]() 3:06:34
3:06:34
![Бандитский Петербург. Все серии подряд. 60fps]() 66:54:01
66:54:01

 2:01:45
2:01:45Скачать Видео с Рутуба по ссылке
| 256x144 | ||
| 426x240 | ||
| 640x360 | ||
| 854x480 | ||
| 1280x720 | ||
| 1920x1080 |
 3:24
3:24
2026-05-15 09:58
 3:52
3:52
2026-05-09 18:11
 4:01
4:01
2026-05-21 11:24
 3:40
3:40
2026-05-22 10:17
 3:44
3:44
2026-04-28 12:53
 3:40
3:40
2026-05-15 10:04
 3:10
3:10
2026-04-29 11:37
 3:14
3:14
2026-05-02 00:31
 3:45
3:45
2026-04-29 14:24
 2:54
2:54
2026-04-29 11:48
 2:50
2:50
2026-06-04 09:50
 4:06
4:06
2026-05-24 15:36
 2:46
2:46
2026-05-24 15:25
 2:34
2:34
2026-05-21 14:31
 2:14
2:14
2026-05-24 15:19
 3:02
3:02
2026-06-04 09:55
 2:44
2:44
2026-06-02 12:46
 3:40
3:40
2026-05-16 13:00
 1:52
1:52
2026-05-15 13:19
 2:53
2:53
2026-05-21 14:27
0/0
 1:26:14
1:26:14
2026-04-07 11:13
 1:53:59
1:53:59
2026-04-22 11:21
 1:39:46
1:39:46
2026-06-01 17:19
 1:52:27
1:52:27
2026-05-20 08:38
 1:37:08
1:37:08
2026-05-07 15:10
 2:06:44
2:06:44
2026-04-22 11:21
 2:15:22
2:15:22
2026-05-21 11:56
 2:16:14
2:16:14
2026-04-20 11:54
 1:21:23
1:21:23
2026-05-28 20:15
 1:37:36
1:37:36
2026-06-01 17:18
 1:35:38
1:35:38
2026-05-20 08:37
 1:23:53
1:23:53
2026-04-17 14:43
 1:39:05
1:39:05
2026-05-07 15:06
 1:54:08
1:54:08
2026-04-13 12:20
 1:35:30
1:35:30
2026-04-30 16:00
 1:51:51
1:51:51
2026-05-06 10:53
 1:46:53
1:46:53
2026-05-26 12:53
 1:38:05
1:38:05
2026-04-12 21:37
 1:30:46
1:30:46
2026-03-28 23:09
 2:36:26
2:36:26
2026-06-01 17:20
0/0
 1:28:31
1:28:31
2026-03-05 13:25
 1:09
1:09
2026-04-03 12:21
2021-09-22 23:36
 13:06
13:06
2024-11-28 16:30
 13:10
13:10
2024-11-27 14:57
 0:12
0:12
2026-04-10 14:28
2021-09-22 20:39
 12:12
12:12
2024-11-29 14:21
2026-06-06 19:10
 12:08
12:08
2025-06-10 14:59
 3:28
3:28
2025-01-09 17:01
2021-09-22 21:43
2021-09-22 22:07
 12:51
12:51
2024-11-27 16:39
2021-09-22 21:03
 11:00
11:00
2026-04-23 16:13
2021-09-22 21:49
 1:02
1:02
2026-05-07 16:57
 0:25
0:25
2026-04-10 13:19
 12:34
12:34
2024-12-02 14:42
0/0
2023-05-31 14:59
 1:49:29
1:49:29
2023-04-27 15:40
 4:33
4:33
2019-12-02 21:15
 2:53
2:53
2025-04-24 09:53
 3:16:51
3:16:51
2025-10-03 19:48
2024-12-16 20:15
2026-01-01 13:59
2024-01-17 17:34
2022-06-06 09:02
2024-01-12 11:40
2025-04-04 18:26
 1:49:18
1:49:18
2026-01-29 11:25
 45:14
45:14
2020-04-22 20:10
2024-12-06 21:59
2022-09-19 10:59
2025-01-13 14:00
 1:38:04
1:38:04
2026-03-26 23:45
2026-02-02 14:57
2024-10-24 16:05
2023-05-15 17:30
0/0

